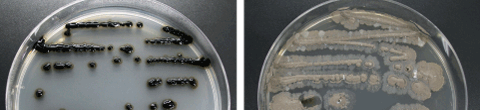
写真(左) Micromonospora chalcea NBRC 12032、写真(右) Streptomyces albulus NBRC 14147
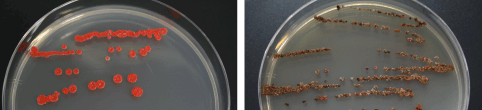
写真(左) Microbispora rosea subsp. nonnitritogenes NBRC 14045、写真(右) Actinophytocola sp. NBRC 14198

NBRCニュース 第30号
◆◇◆ ━━━━━━━━━━━━━━━━━━━━━━━━━━━ ◆◇◆
NBRCニュース No. 30(2014.12.1)
◆◇◆ ━━━━━━━━━━━━━━━━━━━━━━━━━━━ ◆◇◆
NBRCニュース第30号をお届けします。今号は微生物あれこれ、微生物の培養
法、アジアの微生物の3つの連載をお届けします。最後までお読みいただけれ
ば幸いです。
======================================================================
内容
======================================================================
1.平成26年度NBRC微生物実験講習会のご案内
2.新たにご利用可能となった微生物株
3.微生物あれこれ(27)
微細藻類の採集(2)
4.微生物の培養法(15)
放線菌の復元培養法、放線菌は細菌の仲間だけど・・・
5.アジアの微生物 (12)
アジアの発酵食品―ミャンマー編―
6.年末年始のNBRC微生物株・DNAリソースの発送休止について
======================================================================
1.平成26年度NBRC微生物実験講習会のご案内
======================================================================
微生物アンプルの復元・培養や微生物の保存方法等に関する講習会を開催し
ます。日本工業規格(JIS規格)や薬局方に用いられる細菌および糸状菌を用
いて、菌の取り扱いに関する実習を行います。皆様のご参加をお待ちしており
ます。
日時:1. 平成27年1月22日(木)10:30~17:30
2. 平成27年1月23日(金)10:30~17:30
各回、同じ内容です。
場所:製品評価技術基盤機構バイオテクノロジーセンター
千葉県木更津市かずさ鎌足2-5-8
講習内容:微生物アンプルの復元や凍結保存法など(座学および実習)
受講資格:NBRC株のユーザーあるいは今後使用する予定があり、大学等で微
生物の取り扱い経験がある方
募集人数:各回10名(最低履行人数は5名)
定員になり次第、締め切らせていただきます
参加費用:7,900円(税込み)
申込方法:NBRCのホームページに掲載している申込書をダウンロードしてい
ただき、必要事項をご記入のうえ、faxあるいはe-mailでお申し
込みください。
https://www.nite.go.jp//seminar.html
======================================================================
2.新たにご利用可能となった微生物株
======================================================================
◆ NBRC株
酵母 16株、糸状菌 2株、細菌 45株、アーキア 2株、微生物ゲノムDNA 2種
類が新たに利用可能となりました。酵母は酒類蒸溜廃液の処理に利用可能な
Trichosporon属株、トレハロース高生産能を持つTorulaspora delbrueckii、
パン生地に混ぜたまま長期間保存できるパン酵母、低アルコール清酒の生産に
有効な清酒酵母、細菌は薬剤耐性のあるAcinetobacter属の臨床分離株や、ビ
フェニル分解能を持つ株が含まれています。
【NBRC株、ゲノムDNA】
https://www.nite.go.jp/nbrc/cultures/nbrc/new_strain/new_dna.html
◆ RD株
酵母 51株、糸状菌 279株、細菌 523株が新たに利用可能となりました。国
内由来の乳酸菌 30株、モンゴル由来の乳酸菌 58株、ベトナム由来の放線菌
362株が含まれています。詳細はお問合せ下さい。
【RD株】https://www.nite.go.jp/nbrc/cultures/rd/new_rd.html
======================================================================
3.微生物あれこれ(27)
微細藻類の採集(2) (関口弘志)
======================================================================
微細藻類の採集に関して、NBRCニュース第23号に続き、今回は私たちが実際
に行っている方法を紹介いたします。微細藻類を自然界から収集する場合には
(1) 採集、(2) 予備培養、(3) 単離の各ステップが必要となります。更にNBRC
では、単離された微細藻類株の培養特性などの調査を行い、一通りの作業を完
了しています。今回は、各ステップに関して説明します。
(1) 採集
獲得したい微細藻類に合わせて、採集場所を選ぶことが重要です。私は温泉
や温室を対象にすることが多いです。温泉は源泉ごとにpHが非常に異なるため
酸性あるいはアルカリ性の環境下で増殖可能な微細藻類が期待できますし、温
室であれば高温環境下で増殖可能な微細藻類の獲得が期待できます。なお、サ
ンプルの採集許可を得なければならないこともありますので、事前に確認が必
要となります。採集の詳細に関しては、NBRCニュース第23号をご覧ください。

温室および温室に増殖している藻類 (2) 予備培養 多くの場合、持ち帰ったサンプルは予備培養を行い藻類の増殖を待ちます。 我々は予備培養時の条件として、培養温度および培地のpHに着目しています。 培養温度に関しては観察をしながら温度を変更することもあります。特に、従 属栄養性のバクテリアやカビが多く混在しているサンプルでは、これらの微生 物が優占的に増殖してしまい微細藻類を得ることが困難になってしまうため、 予備培養中の観察は非常に重要なものとなります。高温や強酸もしくは強アル カリ条件で増殖する藻類は、生育特性に特徴があることが期待できます。 (3) 単離 基礎編で紹介したとおり、私たちはコロニーピックアップ法で単離を行い、 微細藻類株を確立しています。この他には、希釈法や顕微鏡下で1細胞を釣菌 する方法などがありますが、確実性、作業に求められるスキル、観察や作業に 要する時間やコストの点で一長一短があります。後者は、狙った細胞を拾えま すので確実性は良いのですが、技術が必要で誰もが導入できる手法であるとは いえません。一方、コロニーピックアップ法は容易ではありますが、サンプル によっては純化するまでに時間を要することがあります。 (4) 培養特性の検査 新規に収集した微細藻類株に関しては、培養特性を調べています。酸性(pH 2.0)、中性(pH 6.6)およびアルカリ性(pH 11.5)の培地を分注したプレ ートを、3つの異なる温度(20、29及び38℃)で培養します。私たちは24ウェ ルのマイクロウェルプレートに1.5 mlずつ培地を分注し、単離株を接種したも のを、温度勾配恒温器を用いて培養しています。蛍光プレートリーダーで、各 ウェルの葉緑体の自家蛍光量を毎日測定します。これにより温度やpHに対する 至適培養条件を推定し、増殖速度の情報を得ています。更に現在注目を浴びて いる油脂産生藻類に関しては培養終了時に脂肪染色試薬を培養液に滴下して( 培養液1.5 mlあたり33%ナイルレッド0.02 ml)、脂質の蛍光量を測定し、油脂 産生能についての情報を得ています。これらの情報は簡便な手法で得られたも のであるために、必要に応じてさらに詳細な調査を行ないます。

測定に用いる蛍光プレートリーダー(左)
増殖調査を行ったマイクロウェルプレート(右)
NBRCでは、ユーザーの皆様が希望する微細藻類株の収集と提供に努めており
ます。具体的なご要望がございましたら、お気軽にお問い合わせください。
======================================================================
4.微生物の培養法(15)
放線菌の復元培養法、放線菌は細菌の仲間だけど・・・ (田村朋彦)
======================================================================
放線菌は細菌の一種であり培養方法は細菌と大差はありませんが、L-乾燥標
品(ガラスアンプル)からの復元培養方法には若干の違いがございます。過去
にいただいた放線菌に特有の質問をもとに注意点を紹介します。
◆ L-乾燥標品の復元
NBRCは、ほぼすべての放線菌をL-乾燥標品として提供しています。これまで
のNBRCニュースでも紹介していますが、L-乾燥保存法は菌細胞の懸濁液を凍結
せずに液体から乾燥させる方法で、乾燥すると内容物はガラス管の内側に付着
する傾向があります。放線菌のL-乾燥標品を作製する時には、寒天培地上の気
菌糸や胞子を集めて保存します。しかし、気菌糸や胞子の量が少ない場合には
(これがほとんどです)、寒天培地中に入り込んでいる基生菌糸を含めて作製
する必要があります。このため基生菌糸と一緒に削り取られた培地(寒天)が
アンプルに入ってしまうことが避けられません。これを乾燥すると、乾燥物は
ガラス管内側に強固にこびりつき、復水液を加えてピペッティングするだけで
は細胞を懸濁することができず、復元培養に失敗することがあります。このよ
うな場合はパスルールピペットなどで復水液をアンプルに加えた後に、ピペッ
トの先端でアンプルの内側を何度か軽くこすって乾燥物をはぎ取って懸濁して
から接種してください。力を入れすぎると、パスツールピペットが折れますの
で気をつけてください。最初は強固にこびりついている乾燥物も、水分を含ん
で柔らかくなり、はがれます。アンプルの内側を軽くこすった時に、付着物の
抵抗がなくなれば懸濁完了です。
Micromonospora chalcea NBRC 12032 Streptomyces albulus NBRC 14147 ◆培養 一概に放線菌といっても菌株によって培養日数が異なります。胞子を形成し ない放線菌、CorynebacteriumやMicrococcusの仲間については1~3日、 Streptomycesでは3~7日、その他の放線菌では7~14日ぐらいを目安に培養し てください。活発に生育している菌を新しい培地に継代する場合よりも、L-乾 燥標品から復元する場合には生育に若干時間がかかることもあります。菌株に よっては5日目ぐらいまでは肉眼でコロニーを確認できないこともあります。 液体培地による振盪培養は平板培養より菌が早く生育しますので、場合によっ ては平板培養と同時に液体培養を行うことをお薦めします。37~45℃で培養す る菌株は上記より培養期間が短くなることがあります。その他、培養にあたっ ての注意事項がある場合は、菌株に同封している復元培地組成の説明用紙にコ メントを記載しておりますのでご覧ください。 放線菌は細菌の一種ではありますが形態分化しますので、さまざまな培養性 状を示すことがあります。基生菌糸、気菌糸、胞子の色がそれぞれ異なること があり、1つの平板培養物の中に異なる色のコロニーが出現したり、1つのコロ ニーの色が扇状に異なったりすることがあります。また、可溶性色素が菌体外 に拡散した場合は培地の色が、拡散しない場合は基生菌糸の色が劇的に変化す ることがあります。また、当初は放線菌特有のかさかさしたコロニーだったも のが、培養が進むにつれて菌糸が分断したり、単胞子がコロニー表面を覆った りして、一般細菌の様なコロニーになることがあります。私もコンタミさせた のではないかと何度か冷や汗をかいたことがあり、放線菌の培養物を見慣れて いないと戸惑われるかもしれません。これらの現象が菌株の特徴なのかコンタ ミなのか判別がつきにくい場合、NBRCでは16S rRNA遺伝子塩基配列解析等によ り確認を行っております。 放線菌の胞子形成能は失われやすく、NBRC株の中にも指定培地で生育させた ときに、胞子を作らないものがあります。このような菌株でも、異なる培地に 生育させると胞子を作る場合があります。NBRCでは多種類の菌株を扱っている ため、指定培地を決める際には一般的な培地を優先しており、最適な培地を指 定できていないかもしれません。生育や胞子形成がより良好な培地がわかりま したら、その情報をご連絡いただければ幸いです。菌株の情報として登録し、 活用させていただきたいと存じます。
Microbispora rosea subsp. Actinophytocola sp. NBRC 14198 nonnitritogenes NBRC 14045 【L-乾燥アンプルの復元法】 https://www.nite.go.jp/data/000022144.pdf【PDF307KB】 ====================================================================== 5.アジアの微生物 (12) アジアの発酵食品―ミャンマー編― (大野さやか) ====================================================================== アジアの発酵食品シリーズ第二弾、今回はミャンマーです。南西部の都市パ テインと東部シャン州で見つけた発酵食品をご紹介いたします。ミャンマーで は、これまでに魚貝、野菜、果物、豆、穀物、茶を使った多様な発酵食品に出 会いました。これらの中からユニークな食品とそこから分離された乳酸菌と酵 母を紹介いたします。 ◆ Ngar pi(ンガピ) 生の魚に塩をまぶした後、2~3日間発酵させた塩辛のペースト状の調味料で す。この地域では鯉等の淡水魚がよく使われており、複数の魚を材料にしたも のも売られています。魚以外ではエビも使われ、エビのンガピは魚よりもお値 段が少々高いですが、人気があるようです。パテインでは、朝食としてモヒン ガーという麺料理が有名ですが、そのスープの味付けにンガピが使われていま す。パテインでは必須の調味料だそうですが、東部シャン州では一般的ではな いようです。ンガピからは、乳酸菌はLactobacillus crustorumがすべてのサ ンプルから分離されました。酵母はPichia kudriavzeviiがすべてのサンプル から分離され、その他Candida属やKodamaea属等の酵母が分離されました。 ◆ Ngar chin(ンガチン) Chinは(発酵して)酸っぱいという意味で、漬物には素材+Chinという名が 付けられています。ンガは魚です。ンガチンは魚と米を発酵させたもので、日 本のなれ寿司に似ています。使われる魚はやはり鯉が多いそうです。エビで作 られたものもあり、Pazun Chin(パゾンチン)と呼ばれています。大きなバケ ツで作られるためか塊で店頭に並べられており、好きな重さに切ってもらって 買うことができます。私が買ったときは、「となりのトト○」に出てきたお土 産のように笹の葉で包んで渡してくれました。ンガチンから分離された微生物 は、ンガピと似た傾向を示しました。

Ngar pi(ンガピ) Ngar chin(ンガチン) ◆ Mon nyin chin(モニンチン) モニンは菜の花のことで、モニンチンは菜の花の漬物です。他にも、Myin chin(ミンチン、タケノコの漬物)、Gader chin(ガダーチン、豆の漬物)等 があります。これらからは、乳酸菌はLactobacillus pentosusが多く分離され ました。同じ市場で購入した漬け物からは同じ種類の酵母が分離される傾向が あり、ある市場で購入したものはP. kudriavzeviiが、別の市場ではZygo- saccharomyces pseudobailiiが、また別の市場ではSaccharomyces cerevisiae が複数のサンプルから多く分離されました。いろいろな市場を訪れることで多 様な種類の酵母を集められるのではないかと期待しています。 ◆ Pe poke(ペポ) 豆の発酵食品です。私は納豆が嫌いなので食べていませんが、日本の納豆と 似たにおいがしました。糸は引いていません。生で食べる他、丸い形に潰して 乾燥させたおせんべい型も売っています。パテインでは生のものはあまり見か けませんでしたが、東部では生のものも乾燥されたものもよく食べられている そうです。ペポからはEnterococcus属3種(E. casseliflavus、E. durans、 E. gallinarum)がよく分離された他、Lactobacillus属、Weisella属、 Leuconostoc属等の乳酸菌が分離されました。酵母はあまり分離されませんで した。日本の納豆に似たにおいなので、ペポにもBacillus subtilisなどの微 生物が関わっているかもしれません。

Mon nyin chin(モニンチン) Pe poke(ペポ) ◆ Ka zaw(カゾウ) 米を発酵させたもので、ミャンマー版甘酒です。暖めて飲むそうですが、東 部でしか見つけられず、残念ながら飲む機会がありませんでした。その他には 米が原料の発泡酒がありました。スパークリング日本酒のような味で、おいし かったです。カゾウは1サンプルしか収集できず、酵母はS. cerevisiaeのみ が、乳酸菌はLactobacillus fermentumが分離されました。日本酒のように麹 菌等が活躍している可能性もあるため、次回渡航時はそれらの分離も試みる予 定です。 ◆ Let Fet(ラペ) お茶の葉を蒸してから発酵させた漬物です。ミャンマー全土で食べられてい ますが、主に茶が栽培されている北部で作られています。お隣のタイ北部では ミエンと言う名で似たものが食べられています。スターターとして微生物を加 えることはなく、蒸した茶葉に付着している乳酸菌で自然に発酵させているよ うです。酸っぱい味がしますが、その酸味の程度は作った人や発酵時間で差が でるようで、ミャンマーの方々は市場で試食して好きな味のものを買っていま した。サラダとして食事で食べることもありますが、お茶受けとしてナッツ等 と一緒に食べられることが多いようです。サンプル数がまだ少ないですが、乳 酸菌はLactobacillus paracollinoidesとL. pentosusが、酵母はCandida属が 数種分離されました。

Ka zaw(カゾウ) Let Fet(ラペ) ====================================================================== 6.年末年始のNBRC微生物株・DNAリソースの発送休止について ====================================================================== NBRCでは下記の期間中、お送りする微生物の品質を確保するため、微生物株 とDNAリソースの発送を休止させていただきます。 発送休止期間:平成26年12月19日(金)~平成27年1月5日(月) 12/17(水)午前まで受付分 → 12/18(木)発送予定 12/17(水)午後~12/26(金)まで受付分 → 1/ 6(火)発送予定 12/27(土)以降の受付分 → 1/ 8(木)発送予定 また、上記期間中にお急ぎでご利用になりたい場合は電話(0438-20-5763) にてご相談ください。なお年内の営業日は12月26日(金)まで、年始は1月5日 (月)からとなっています。 【生物遺伝資源の提供・寄託について】 https://www.nite.go.jp/nbrc/cultures/index.html ====================================================================== 編集後記 ====================================================================== NBRCは千葉県木更津市の房総丘陵にあります。先日、木更津市主催の歩け歩 け大会に参加しNBRCの近くを散策しました。市中心部からNBRCまでは自動車で はあっという間ですが、田んぼの間の小路を自分の足で歩いてみると子供の頃 に田舎に遊びに行ったような気分になり、時が止まったように思えました。穏 やかな秋の一日でした。(HS) ◆◇◆ ━━━━━━━━━━━━━━━━━━━━━━━━━━━ ◆◇◆ ・受信アドレス変更、受信停止は以下のサイトからお手続きください。 https://www.nite.go.jp/nbrc/cultures/others/nbrcnews/nbrcnews.html ・NBRCニュースは配信登録いただいたメールアドレスにお送りしております。 万が一間違えて配信されておりましたら、お手数ですが、下記のアドレスに ご連絡ください。 ・ご質問、転載のご要望など、NBRCニュースについてのお問い合わせは、下記 のアドレスにご連絡ください。 ・掲載内容は予告なく変更することがございます。掲載内容を許可なく複製・ 転載されることを禁止します。 ・偶数月の1日(休日の場合はその前後)に配信します。第31号は2月2日に配 信予定です。 編集・発行 独立行政法人製品評価技術基盤機構(NITE)バイオテクノロジーセンター NBRCニュース編集局(nbrcnews@nite.go.jp) ◆◇◆ ━━━━━━━━━━━━━━━━━━━━━━━━━━━ ◆◇◆
PDFファイルをご覧いただくためには、Adobe Reader(無償)が必要です。Adobe Readerはダウンロードページ
よりダウンロードできます。
お問い合わせ
-
独立行政法人製品評価技術基盤機構 バイオテクノロジーセンター
生物資源利用促進課
(お問い合わせはできる限りお問い合わせフォームにてお願いします) -
TEL:0438-20-5763
住所:〒292-0818 千葉県木更津市かずさ鎌足2-5-8 地図
お問い合わせフォームへ








